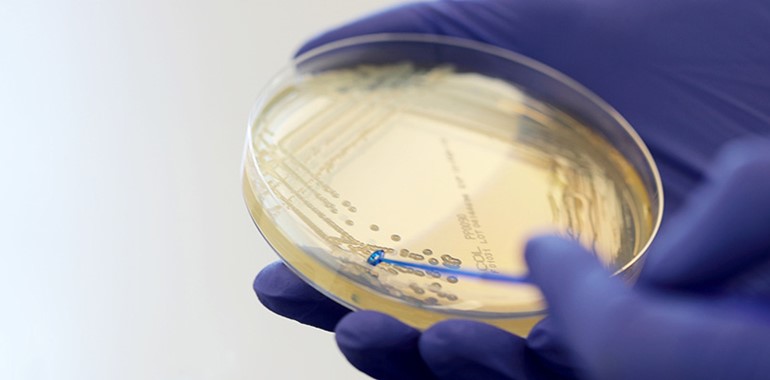

Nitroxoline Exhibits Excellent Activity in CPE Infections
Gram negative bacteria that are resistant to carbapenems are considered to be an urgent global threat. Carbapenemase producing Enterobacterales (CPE) pose patients at risk of potentially untreatable infections. Nitroxoline is an old antibiotic that has been in use in Europe for >50 years, but has recently been re-launched for the treatment of uncomplicated urinary tract infections. A recent study by Fuchs and Hamprecht (2019) to analyse the in vitro activity of nitroxoline against CPE showed that 95% of carbapenemase producers, producing OXA-48-like, VIM, IMI, IMP, NDM, KPC, OXA-58 and GES would be classified as susceptible.
Fuchs and Hamprecht (2019) concluded that ‘Nitroxoline could therefore be an alternative oral option for treatment of uncomplicated urinary tract infections caused by CPE’.
Nitroxoline 30µg cartridge discs (NIB30C) are available as part of Mast Group Ltd’s stock range of discs, each pack containing 5 x 50 discs (250 tests), and compatible with the MAST® DISCMASTER Dispenser (MDD65).
For more information about this or the full range of AMR and AST products please contact us using the button at the bottom of this page.
Fuchs F, Hamprecht A. Susceptibility of carbapenemase-producing Enterobacterales (CPE) to nitroxoline. J Antimicrob Chemother. 2019 Jul 10. pii: dkz275. doi: 10.1093/jac/dkz275. [Epub ahead of print] PubMed PMID: 31292653.